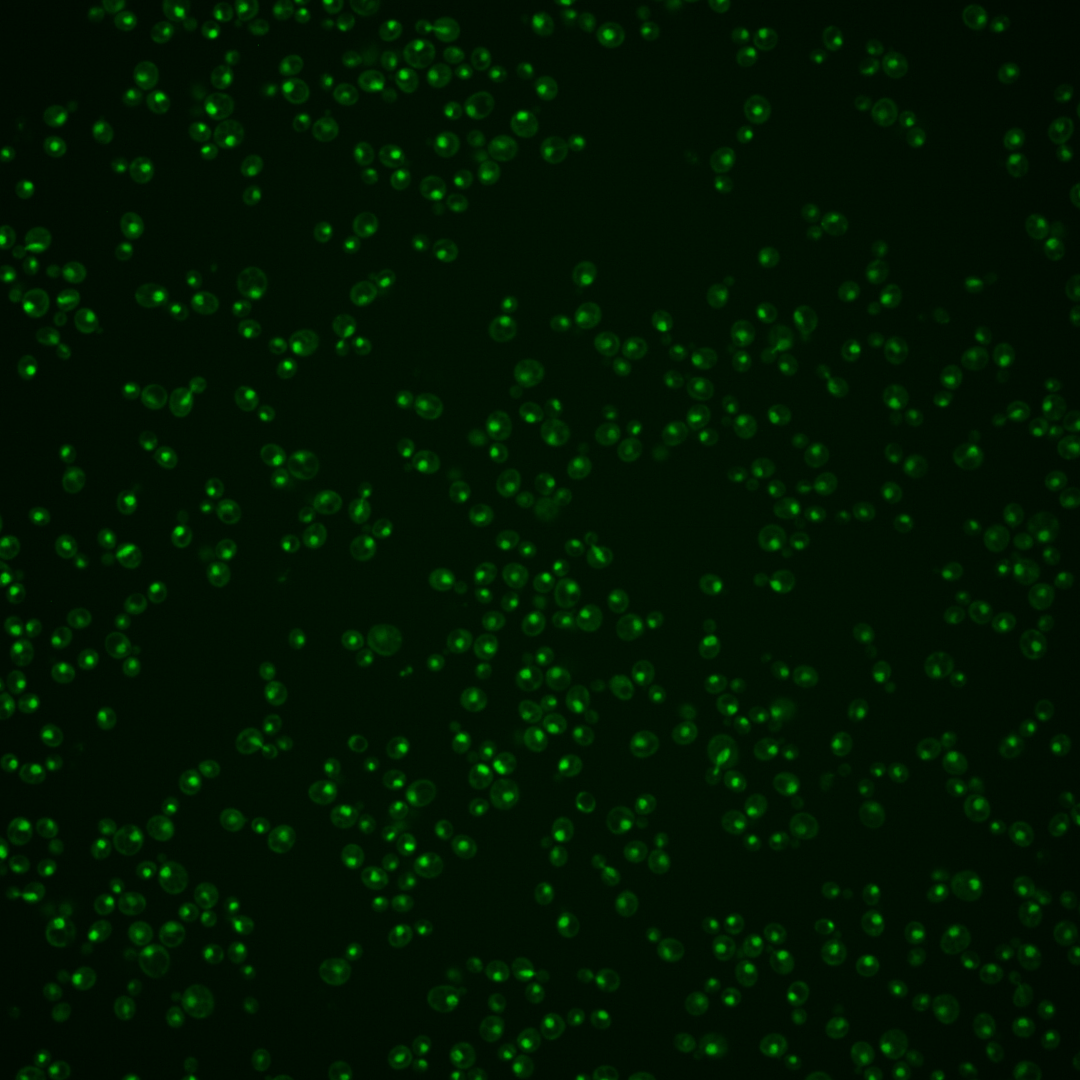

| Standard name | |
|---|---|
| Human Ortholog | |
| Description | Histone deacetylase, component of both the Rpd3S and Rpd3L complexes; regulates transcription, silencing, autophagy and other processes by influencing chromatin remodeling; forms at least two different complexes which have distinct functions and members; Rpd3(L) recruitment to the subtelomeric region is regulated by interaction with the arginine methyltransferase, Hmt1p |
Micrographs




















































































Sub-cellular Localization
Yeast GFP Assignment
Protein Abundance
Localization Change
External localization resources
| ensLOC | DeepLoc | |||||||||||||||||||||||
|---|---|---|---|---|---|---|---|---|---|---|---|---|---|---|---|---|---|---|---|---|---|---|---|---|
| Localization | WT1 | WT2 | WT3 | RAP60 | RAP140 | RAP220 | RAP300 | RAP380 | RAP460 | RAP540 | RAP620 | RAP700 | HU80 | HU120 | HU160 | rpd3Δ_1 | rpd3Δ_2 | rpd3Δ_3 | WT1 | WT2 | WT3 | AF100 | AF140 | AF180 |
| Cortical Patches | 0 | 0 | 0 | 0 | 0 | 0 | 0 | 0 | 0 | 0 | 0 | 0 | 0 | 0 | 0 | – | – | – | 0 | 1 | 0 | 0 | 0 | 0 |
| Bud | 0 | 0 | 0 | 0 | 2 | 3 | 12 | 7 | 2 | 3 | 2 | 3 | 0 | 0 | 0 | – | – | – | 1 | 4 | 6 | 3 | 4 | 4 |
| Bud Neck | 0 | 0 | 0 | 0 | 1 | 1 | 4 | 5 | 0 | 0 | 4 | 3 | 0 | 0 | 0 | – | – | – | 0 | 0 | 2 | 1 | 0 | 2 |
| Bud Site | 0 | 0 | 1 | 0 | 2 | 11 | 22 | 16 | 13 | 21 | 24 | 19 | 0 | 0 | 0 | – | – | – | – | – | – | – | – | – |
| Cell Periphery | 0 | 0 | 0 | 0 | 0 | 0 | 0 | 0 | 0 | 0 | 0 | 0 | 0 | 1 | 0 | – | – | – | 0 | 0 | 0 | 0 | 0 | 0 |
| Cytoplasm | 1 | 4 | 10 | 13 | 25 | 15 | 15 | 23 | 9 | 4 | 4 | 7 | 37 | 66 | 83 | – | – | – | 0 | 1 | 2 | 5 | 4 | 7 |
| Endoplasmic Reticulum | 0 | 1 | 1 | 0 | 1 | 0 | 0 | 0 | 0 | 0 | 0 | 0 | 0 | 0 | 1 | – | – | – | 0 | 0 | 0 | 0 | 1 | 2 |
| Endosome | 0 | 2 | 13 | 1 | 3 | 2 | 2 | 2 | 0 | 0 | 0 | 0 | 1 | 1 | 3 | – | – | – | 3 | 1 | 11 | 5 | 8 | 13 |
| Golgi | 0 | 0 | 0 | 0 | 0 | 0 | 0 | 0 | 0 | 0 | 0 | 0 | 0 | 0 | 0 | – | – | – | 3 | 2 | 1 | 0 | 1 | 2 |
| Mitochondria | 40 | 7 | 6 | 15 | 13 | 94 | 122 | 56 | 43 | 98 | 118 | 90 | 1 | 0 | 1 | – | – | – | 1 | 0 | 1 | 1 | 5 | 5 |
| Nucleus | 152 | 218 | 443 | 230 | 281 | 463 | 472 | 442 | 340 | 380 | 411 | 440 | 447 | 445 | 376 | – | – | – | 119 | 199 | 317 | 319 | 302 | 290 |
| Nuclear Periphery | 0 | 0 | 4 | 2 | 2 | 5 | 10 | 11 | 7 | 6 | 8 | 8 | 0 | 2 | 0 | – | – | – | 0 | 0 | 4 | 1 | 3 | 2 |
| Nucleolus | 52 | 48 | 61 | 44 | 61 | 166 | 221 | 250 | 202 | 252 | 315 | 345 | 27 | 19 | 24 | – | – | – | 48 | 61 | 166 | 53 | 69 | 109 |
| Peroxisomes | 0 | 0 | 0 | 1 | 0 | 0 | 0 | 0 | 0 | 0 | 0 | 0 | 0 | 0 | 5 | – | – | – | 0 | 0 | 1 | 0 | 0 | 0 |
| SpindlePole | 0 | 1 | 4 | 0 | 0 | 1 | 2 | 0 | 0 | 2 | 1 | 1 | 6 | 13 | 10 | – | – | – | 2 | 1 | 13 | 10 | 8 | 20 |
| Vac/Vac Membrane | 3 | 14 | 3 | 1 | 5 | 9 | 6 | 4 | 3 | 5 | 2 | 3 | 1 | 4 | 4 | – | – | – | 6 | 8 | 17 | 16 | 25 | 28 |
| Unique Cell Count | 183 | 254 | 497 | 263 | 348 | 605 | 649 | 663 | 482 | 578 | 631 | 672 | 496 | 528 | 481 | 191 | 284 | 549 | 428 | 444 | 497 | |||
| Labelled Cell Count | 248 | 295 | 546 | 307 | 396 | 770 | 888 | 816 | 619 | 771 | 889 | 919 | 520 | 551 | 507 | 191 | 284 | 549 | 428 | 444 | 497 | |||
Yeast GFP Assignment
Protein Abundance
| Screen | WT1 | WT2 | WT3 | RAP60 | RAP140 | RAP220 | RAP300 | RAP380 | RAP460 | RAP540 | RAP620 | RAP700 | HU80 | HU120 | HU160 | rpd3Δ_1 | rpd3Δ_2 | rpd3Δ_3 | AF100 | AF140 | AF180 |
|---|---|---|---|---|---|---|---|---|---|---|---|---|---|---|---|---|---|---|---|---|---|
| Mean Cell GFP Intensity (1e-4) | 6.4 | 8.8 | 7.8 | 7.2 | 7.6 | 6.8 | 6.8 | 6.9 | 7.2 | 7.2 | 6.6 | 6.8 | 9.4 | 9.2 | 8.6 | – | – | – | 8.8 | 8.9 | 9.4 |
| Std Deviation (1e-4) | 1.3 | 1.3 | 1.7 | 2.2 | 2.2 | 2.1 | 1.8 | 2.0 | 2.1 | 2.1 | 2.2 | 1.8 | 1.6 | 1.7 | 1.7 | – | – | – | 1.4 | 1.4 | 1.8 |
| Intensity Change (Log2) | – | – | – | -0.11 | -0.04 | -0.19 | -0.2 | -0.16 | -0.11 | -0.11 | -0.23 | -0.18 | 0.28 | 0.25 | 0.15 | – | – | – | 0.18 | 0.2 | 0.27 |
Localization Change
| Localization | RAP60 | RAP140 | RAP220 | RAP300 | RAP380 | RAP460 | RAP540 | RAP620 | RAP700 | HU80 | HU120 | HU160 | rpd3Δ_1 | rpd3Δ_2 | rpd3Δ_3 |
|---|---|---|---|---|---|---|---|---|---|---|---|---|---|---|---|
| Cortical Patches | 0 | 0 | 0 | 0 | 0 | 0 | 0 | 0 | 0 | 0 | 0 | 0 | – | – | – |
| Bud | 0 | 0 | 0 | 3.0 | 0 | 0 | 0 | 0 | 0 | 0 | 0 | 0 | – | – | – |
| Bud Neck | 0 | 0 | 0 | 0 | 0 | 0 | 0 | 0 | 0 | 0 | 0 | 0 | – | – | – |
| Bud Site | 0 | 0 | 2.6 | 3.8 | 3.1 | 3.3 | 4.0 | 4.1 | 3.4 | 0 | 0 | 0 | – | – | – |
| Cell Periphery | 0 | 0 | 0 | 0 | 0 | 0 | 0 | 0 | 0 | 0 | 0 | 0 | – | – | – |
| Cytoplasm | 2.2 | 3.7 | 0.5 | 0.3 | 1.5 | -0.2 | -1.9 | -2.1 | -1.4 | 4.0 | 6.4 | 8.1 | – | – | – |
| Endoplasmic Reticulum | 0 | 0 | 0 | 0 | 0 | 0 | 0 | 0 | 0 | 0 | 0 | 0 | – | – | – |
| Endosome | 0 | -1.8 | -3.3 | -3.4 | -3.5 | -3.6 | -3.9 | -4.1 | -4.2 | -3.2 | -3.3 | -2.5 | – | – | – |
| Golgi | 0 | 0 | 0 | 0 | 0 | 0 | 0 | 0 | 0 | 0 | 0 | 0 | – | – | – |
| Mitochondria | 3.6 | 2.4 | 8.2 | 9.4 | 5.4 | 5.5 | 8.7 | 9.3 | 7.5 | 0 | 0 | 0 | – | – | – |
| Nucleus | -0.7 | -3.4 | -5.4 | -6.9 | -8.9 | -7.3 | -9.0 | -9.3 | -9.3 | 0.5 | -2.3 | -4.6 | – | – | – |
| Nuclear Periphery | 0 | 0 | 0 | 1.1 | 1.3 | 1.0 | 0 | 0.8 | 0.6 | 0 | 0 | 0 | – | – | – |
| Nucleolus | 1.7 | 2.1 | 6.2 | 8.5 | 9.7 | 10.5 | 11.3 | 13.3 | 13.9 | -3.8 | -5.2 | -4.0 | – | – | – |
| Peroxisomes | 0 | 0 | 0 | 0 | 0 | 0 | 0 | 0 | 0 | 0 | 0 | 0 | – | – | – |
| SpindlePole | 0 | 0 | 0 | 0 | 0 | 0 | 0 | 0 | 0 | 0 | 2.1 | 1.7 | – | – | – |
| Vacuole | 0 | 0 | 1.4 | 0 | 0 | 0 | 0 | 0 | 0 | 0 | 0 | 0 | – | – | – |
External localization resources
Images






























Protein Concentration and Protein Localization Data
| R1 | R2 | R3 | ||||||||||||||||
|---|---|---|---|---|---|---|---|---|---|---|---|---|---|---|---|---|---|---|
| G1 Pre-START | G1 Post-START | S/G2 | Metaphase | Anaphase | Telophase | G1 Pre-START | G1 Post-START | S/G2 | Metaphase | Anaphase | Telophase | G1 Pre-START | G1 Post-START | S/G2 | Metaphase | Anaphase | Telophase | |
| Concentration | 7.3829 | 7.3276 | 6.8896 | 6.2458 | 6.5355 | 6.3343 | 5.6469 | 5.6369 | 5.4087 | 4.8523 | 4.5993 | 5.4717 | 5.8471 | 5.3352 | 4.9264 | 5.3245 | 4.4619 | 4.7559 |
| Actin | 0.0003 | 0 | 0.0001 | 0 | 0.0001 | 0 | 0.0265 | 0 | 0.0049 | 0 | 0.102 | 0.0008 | 0.0032 | 0 | 0.0055 | 0 | 0.0413 | 0 |
| Bud | 0.0001 | 0 | 0 | 0 | 0.0001 | 0 | 0.0013 | 0 | 0.0003 | 0 | 0.0077 | 0.0004 | 0.0005 | 0 | 0.0002 | 0 | 0.0002 | 0.0001 |
| Bud Neck | 0.0005 | 0.0001 | 0.0001 | 0 | 0.0003 | 0.0007 | 0.0018 | 0.0002 | 0.0004 | 0 | 0.001 | 0.0014 | 0.0003 | 0.0001 | 0.0002 | 0 | 0.0007 | 0.0008 |
| Bud Periphery | 0.0002 | 0 | 0.0001 | 0 | 0.0003 | 0.0001 | 0.0017 | 0 | 0.0007 | 0 | 0.0139 | 0.0009 | 0.0006 | 0 | 0.0002 | 0 | 0.0005 | 0.0001 |
| Bud Site | 0.0003 | 0.0001 | 0.0001 | 0 | 0.0003 | 0.0001 | 0.0123 | 0.0001 | 0.0121 | 0 | 0.007 | 0.0007 | 0.0022 | 0 | 0.0012 | 0 | 0.0005 | 0.0001 |
| Cell Periphery | 0 | 0 | 0 | 0 | 0.0001 | 0 | 0.0004 | 0 | 0.0008 | 0 | 0.0002 | 0.0002 | 0 | 0 | 0.0001 | 0 | 0.0001 | 0 |
| Cytoplasm | 0.001 | 0.0001 | 0.0004 | 0 | 0 | 0 | 0.0041 | 0.0001 | 0.0004 | 0 | 0.0004 | 0.0005 | 0.0057 | 0 | 0.0087 | 0 | 0.0001 | 0 |
| Cytoplasmic Foci | 0.0001 | 0 | 0.0002 | 0 | 0 | 0 | 0.05 | 0 | 0.0035 | 0 | 0.0065 | 0.0027 | 0.016 | 0 | 0.0047 | 0 | 0.0003 | 0 |
| Eisosomes | 0 | 0 | 0 | 0 | 0 | 0 | 0.0003 | 0 | 0 | 0 | 0.0002 | 0 | 0 | 0 | 0 | 0 | 0.0005 | 0 |
| Endoplasmic Reticulum | 0.0005 | 0 | 0.0002 | 0 | 0 | 0 | 0.0017 | 0 | 0 | 0 | 0.0004 | 0.0005 | 0.002 | 0 | 0.0062 | 0 | 0.0032 | 0 |
| Endosome | 0.0006 | 0 | 0.002 | 0 | 0.0001 | 0 | 0.02 | 0 | 0.0002 | 0 | 0.0094 | 0.0067 | 0.018 | 0 | 0.0067 | 0 | 0.005 | 0 |
| Golgi | 0 | 0 | 0.0005 | 0 | 0 | 0 | 0.0112 | 0 | 0.0005 | 0 | 0.0211 | 0.0014 | 0.005 | 0 | 0.0042 | 0 | 0.0073 | 0 |
| Lipid Particles | 0 | 0 | 0.0056 | 0 | 0.0001 | 0 | 0.0202 | 0 | 0.0003 | 0 | 0.0054 | 0.0008 | 0.005 | 0 | 0.0016 | 0 | 0.0016 | 0 |
| Mitochondria | 0.0007 | 0.0001 | 0.0019 | 0 | 0.0011 | 0.0001 | 0.0105 | 0.0001 | 0.0003 | 0.0001 | 0.0184 | 0.012 | 0.0019 | 0.0001 | 0.0098 | 0.0001 | 0.0109 | 0.0001 |
| None | 0.0002 | 0 | 0.0014 | 0 | 0.0001 | 0 | 0.003 | 0 | 0.0001 | 0 | 0.0003 | 0.0001 | 0.0024 | 0 | 0.0023 | 0 | 0.0004 | 0 |
| Nuclear Periphery | 0.0072 | 0.0036 | 0.0048 | 0.0001 | 0.0012 | 0.0001 | 0.0017 | 0.0002 | 0.0004 | 0.0002 | 0.0009 | 0.0011 | 0.0058 | 0.0003 | 0.01 | 0.0003 | 0.0052 | 0.0002 |
| Nucleolus | 0.055 | 0.0375 | 0.0335 | 0.0142 | 0.2228 | 0.111 | 0.0552 | 0.0288 | 0.0318 | 0.0185 | 0.1235 | 0.1263 | 0.0275 | 0.0318 | 0.0282 | 0.0311 | 0.2586 | 0.1129 |
| Nucleus | 0.927 | 0.9499 | 0.9466 | 0.9854 | 0.7694 | 0.8809 | 0.7392 | 0.9696 | 0.9367 | 0.9811 | 0.672 | 0.8288 | 0.8722 | 0.967 | 0.902 | 0.9684 | 0.6606 | 0.8848 |
| Peroxisomes | 0 | 0 | 0.0002 | 0 | 0.0001 | 0 | 0.0251 | 0 | 0.0032 | 0 | 0.0058 | 0.0118 | 0.0055 | 0 | 0.0011 | 0 | 0.0003 | 0 |
| Punctate Nuclear | 0.0052 | 0.0083 | 0.0009 | 0.0002 | 0.0035 | 0.0069 | 0.0105 | 0.0008 | 0.0031 | 0.0001 | 0.0024 | 0.0007 | 0.0253 | 0.0005 | 0.0062 | 0.0001 | 0.0015 | 0.0007 |
| Vacuole | 0.0007 | 0.0001 | 0.0007 | 0 | 0.0002 | 0.0001 | 0.0025 | 0 | 0.0004 | 0 | 0.0008 | 0.0015 | 0.0005 | 0 | 0.0007 | 0 | 0.0004 | 0.0001 |
| Vacuole Periphery | 0.0003 | 0 | 0.0009 | 0 | 0.0002 | 0 | 0.0007 | 0 | 0.0001 | 0 | 0.0006 | 0.0008 | 0.0004 | 0 | 0.0005 | 0 | 0.0008 | 0 |
Sequencing Data
| R1 | R2 | |||||||||
|---|---|---|---|---|---|---|---|---|---|---|
| G1 Post-START | S/G2 | Metaphase | Anaphase | Telophase | G1 Post-START | S/G2 | Metaphase | Anaphase | Telophase | |
| Gene Expression | 29.6614 | 34.8489 | 30.3567 | 38.6779 | 39.0067 | 39.809 | 31.4057 | 40.3255 | 43.4485 | 41.5864 |
| Translational Efficiency | 1.3518 | 0.9308 | 0.9222 | 0.837 | 0.8836 | 0.8526 | 1.2301 | 0.7592 | 0.8084 | 0.9549 |
Hit Data
| Dataset | Hit |
|---|---|
| Protein Concentration | ✘ |
| Protein Localization | ✘ |
| Gene Expression | ✘ |
| Translational Efficiency | ✘ |
Endocytosis
| Temp | Actin Patch (Sac6-tdTomato) | Cortical Patch (Sla1-GFP) | Late Endosome (Snf7-GFP) | Vacuole (Vph1-GFP) |
|---|---|---|---|---|
| 37℃ | ||||
| RT |
Cell Cycle Omics
CYCLoPs (Rpd3-GFP)
| Gene / Allele | Actin Patch (Sac6-tdTomato) | Cortical Patch (Sla1-GFP) | Late Endosome (Snf7-GFP) | Vacuole (Sac6-tdTomato) |
|---|
| Gene | Images |
|---|
| Gene | Images |
|---|
Images are not yet available
Images are not yet available